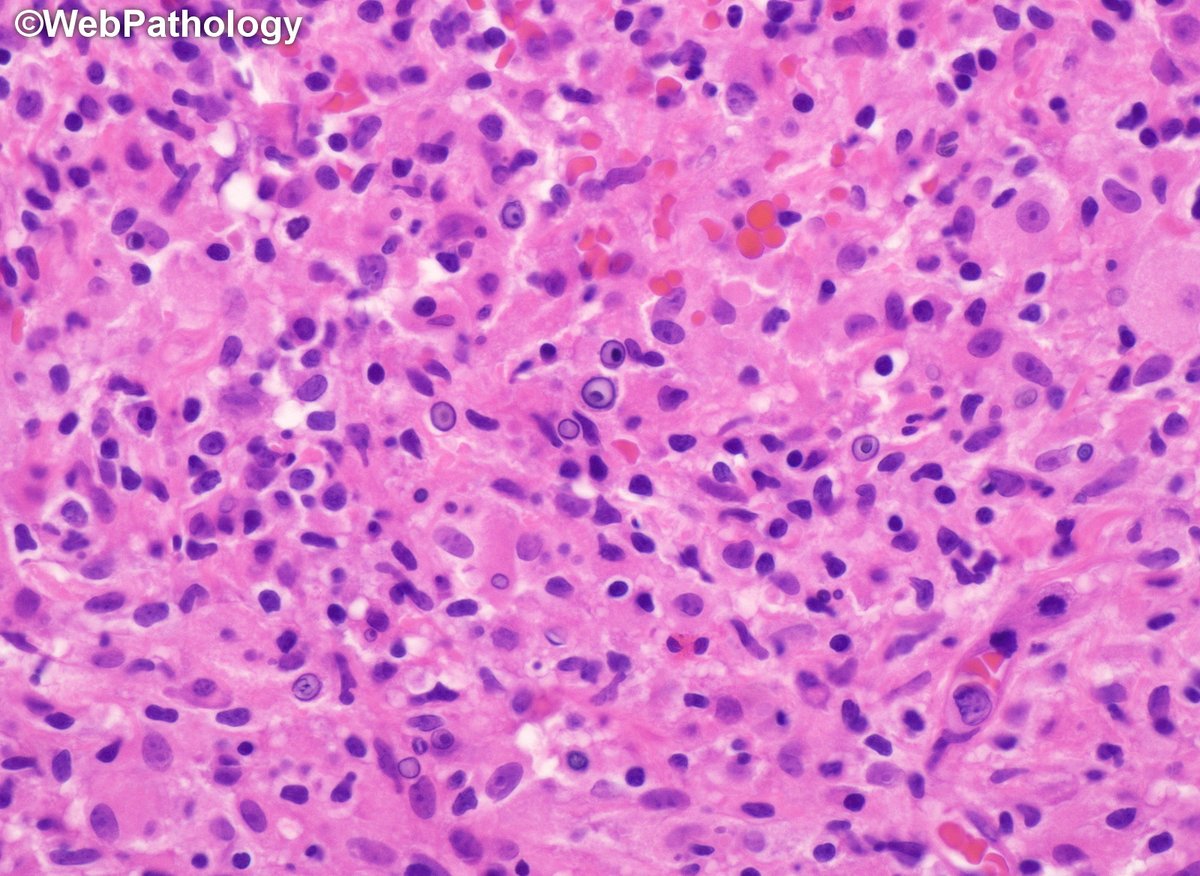
WebPathology tweet media

پن کیا گیا ٹویٹ

Welcome to StainsFile by @STEMCELLTech! Here, you can enjoy easy and open access to all the protocols and supporting resources you need to help you fix, prepare, and stain specimens: stainsfile.com 👩🏽🔬💻🧫🔬
#cellstaining #histology #microscopy #microscopymonday
English